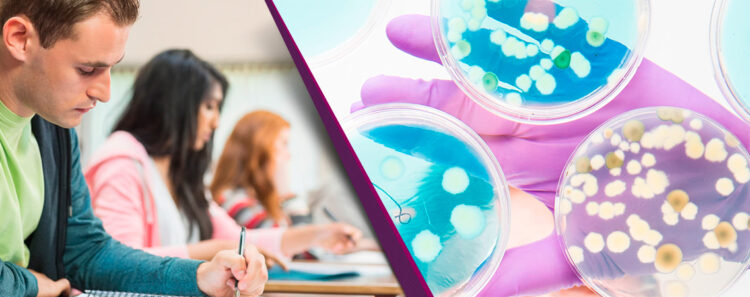

Las Infecciones Asociadas a la Atención de la Salud (IAAS), o infecciones nosocomiales, se consideran uno de los mayores retos para la seguridad paciente y un factor que obstaculiza la calidad en la prestación de la atención médica en los servicios de salud.
Dichos temas se debatirán por especialistas del más alto nivel en el XXVII Congreso Internacional de la Asociación Mexicana para el Estudio de las Infecciones Nosocomiales, A.C. AMEIN, a celebrarse del 8 al 11 de marzo de 2023 en Ciudad de México.
De acuerdo con la Organización Mundial de la Salud (OMS), las Infecciones Asociadas a la Atención de la Salud (IAAS), se definen como aquellas infecciones que afectan a un paciente durante el proceso de asistencia en un hospital o centro sanitario, que no estaba presente, ni en período de incubación al momento de su ingreso y que pueden, inclusive, llegar a manifestarse después del alta del paciente.
Actualmente en México, la vigilancia epidemiológica de las Infecciones Asociadas a la Atención de la Salud (IAAS), está regulada en la norma oficial NOM-045-SSA2-2005, la cual estipula que los hospitales públicos y privados deben reportarlas a la Red de Vigilancia Epidemiológica (RHOVE).
La Red de Vigilancia Epidemiológica Hospitalaria (RHOVE), sistema de vigilancia centinela, que forma parte de los Sistemas Especiales del Sistema Nacional de Vigilancia Epidemiológica (SINAVE), es el responsable de unificar los criterios para la recopilación de la información generada a través de las 353 unidades hospitalarias que conforman la RHOVE, con la participación de unidades de salud del sector público y privado del país.
Sin embargo, menos del 10 por ciento de las unidades hospitalarias en todo el país, reportan periódicamente la incidencia de infecciones asociadas a la atención a la salud (IAAS), de acuerdo con en el artículo “Frecuencia de infecciones asociadas a la atención de la salud en los principales sistemas de información de México” publicado por la Comisión Nacional de Arbitraje Médico (COMAMED) y la Organización Panamericana de la Salud (OPS) en 2018 , que utiliza datos oficiales de la Secretaría de Salud Federal.
Otras cifras relevantes del mismo estudio muestran que en México, “en promedio, los pacientes que presentaron IAAS permanecieron hospitalizados 21.5 días y casi 20% egresó por defunción”.
A nivel mundial y, de acuerdo con un informe reciente de la Organización Mundial de la Salud (OMS), revela que actualmente en los países de ingreso alto, 7 de cada 100 pacientes ingresados en un hospital de cuidados intensivos contraerán al menos una infección nosocomial durante su hospitalización; cifra que asciende a 15 de cada 100 en los países de ingreso bajo o mediano. Es decir, que 1 de cada 10 pacientes afectados fallecerá por una infección nosocomial. Los ingresados en cuidados intensivos y recién nacidos están particularmente expuestos a este riesgo.
Ante este panorama la OMS es categórica al asegurar que si se siguen prácticas adecuadas en materia de higiene de las manos y en función de los costos, el 70% de esas infecciones pueden prevenirse.
La pandemia de COVID-19 y otros brotes epidémicos recientes como la viruela símica, expusieron la medida en que los centros de salud pueden contribuir a la propagación de infecciones, sin embargo, también representa una oportunidad para reforzar los programas de prevención y control de infecciones en todo el sistema de salud.
De acuerdo con el Dr. Alejandro Macías, profesor titular del área de microbiología y enfermedades infecciosas del Departamento de Medicina y Nutrición de la Universidad de Guanajuato “una de las lecciones que ha dejado la pandemia es que toda esta evolución de la epidemiología, del control y prevención de infecciones en los hospitales, es sin duda un área de muy intenso trabajo y de un cambio constante, pero que ahora se va a acelerar, a consecuencia de lo que causó la pandemia, pero también de lo que entendimos gracias a la pandemia”.
El Dr. Alejandro Macías, forma parte de los especialistas que participarán en el XXVII Congreso Internacional de la Asociación Mexicana para el Estudio de las Infecciones Nosocomiales, A.C. (AMEIN): “Cuando la Calidad enfrenta una nueva realidad en prevención“, a celebrarse del 8 al 11 de marzo de 2023 en la Ciudad de México.
Entre los temas que debatirán especialistas del más alto nivel destacan: ”Las IAAS hoy en México”, Red de Vigilancia Epidemiológica Hospitalaria (RHOVE); Hospital Limpio: desafíos y perspectivas; Actualización de procesos, transición de la CeyE al DPE; Riesgo de infecciones en la anestesia de pacientes obstétricos; Ventilación y aire seguro en los hospitales; Hacia donde vamos: Liderazgo